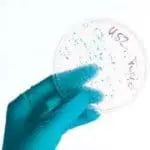

Preservatives In Natural Skincare: Is Phenoxythanol Safe?
Share
Preservatives In Natural Skincare: Is Phenoxythanol Safe?
Is Phenoxythanol Safe?
Thanks to documentaries like “The Human Experiment” on Netflix, most of us have become a lot more aware of the insidious chemicals lurking in our household products disguised in harmless looking packaging. All you have to do is pick up a commercial drugstore product and look at the long list of tongue-twisting ingredients to see my point. The same is true when it comes to our skincare products, many of which use phenoxyethanol as a preservative, but is phenoxyethonal safe?
You might have heard the saying “If you can’t pronounce it, don’t use it”, but did you know that some preservatives are essential, even in natural products such as ours, to prevent deadly bacteria from forming?
In order to prevent the use of harmful chemicals such as parabens, we use a safer preservative called Phenoxyethanol.
What is it and is phenoxyethanol safe as a natural skincare preservative?
Don’t let the name scare you.
This is one preservative, that when used in small doses, poses no threat to your health whatsoever. Phenoxyethanol is naturally occurring in green tea, however the commercial ingredient is made in a laboratory from alkyl ethers of ethylene glycol.
Its main purpose is to stave off the presence and/or growth of bacteria in cosmetic products. Any product that contains water, such as body lotion, has a high risk of developing dangerous bacteria that can pose a serious threat to your health.
This is why Phenoxyethanol is essential for preventing this and keeping our products safe.
You will notice that some of our products, such as our lip balms and Vegan Vapor Rub do not contain Phenoxyethanol simply because these products do not contain any water.
Is Phenoxyethanol Safe?
According to a study in the International Journal of Toxicology, the low percentage (in general less than 2 percent) of phenoxyethanol in cosmetics is safe and non toxic to humans. Of note, at Lowen’s we use a concentration of Phenoxyethanol at less than 1%!
At Lowen’s, our concentrations are lower than 1 percent.
High concentrations may cause issues like rashes, but our concentrations are far too low for you to ever have to worry about this.
It’s like anything in life. Too much of a good thing is usually not good for you.
You wouldn’t eat donuts every day all day long, because this would negatively impact your health and you would feel pretty awful. The same goes for Phenoxyethanol; high concentrations in commercial drugstore cosmetics may cause sensitivity, but the incredibly low concentrations we use pose no risk.
Can my kids use it?
If we deem our products safe to use, we mean they are safe for everybody! In fact, Lowen’s was named after our daughter, Lowen, who was the inspiration for all of our products due to a recurring diaper rash that no commercial product would treat.
This is how our first product, a natural chemical-free diaper balm was born.
The bottom line…
We use only organic, fair trade, natural preservatives as ingredients in our skincare.
We don’t believe in a shopping list of ingredients in our products, but rather simple, natural ingredients that deliver the expected results without the use of chemicals.
Phenoxyethanol is the only preservative we use in our water-based products and the concentrations are so low, we can guarantee it is perfectly safe to use. We use this preservative to keep our products free of harmful bacteria and safe for use on everyone in your family.
If it’s safe for us, it’s safe for you too, because we don’t bring any products to the market until they have been tested on ourselves first!